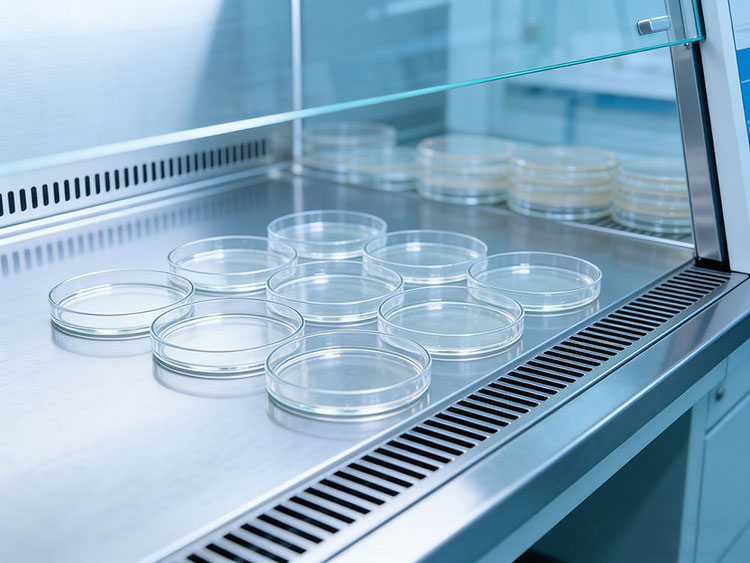
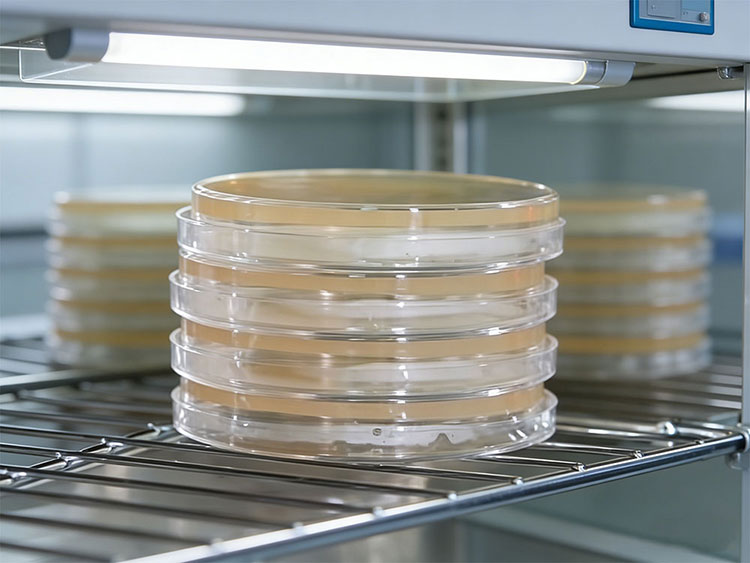
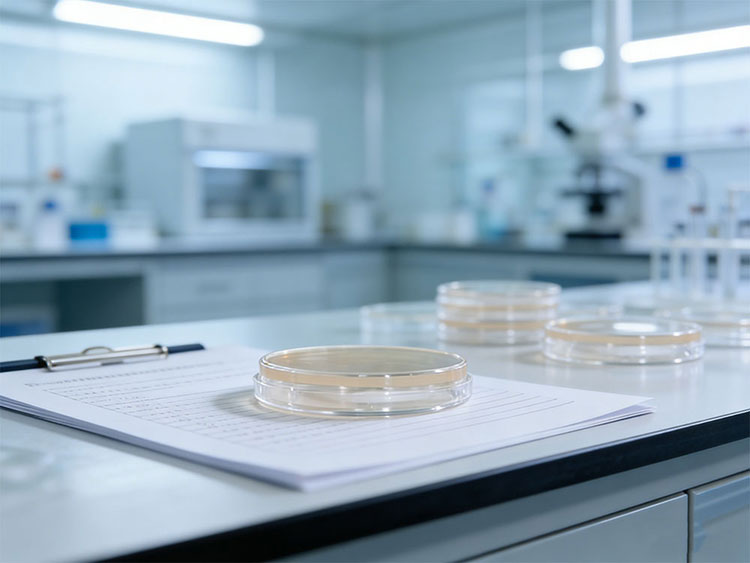

在制藥行業,浮游菌采樣器至關重要,它不是一項“可選”的輔助設備,而是與藥品安全、法律合規性直接相關的關鍵生產環節。
對制藥企業而言,浮游菌采樣是一項強制性的合規要求。中國《藥品生產質量管理規范》(GMP)及國際標準(如ISO 14698)明確要求,對潔凈室的空氣微生物(浮游菌)進行監控。它是證明生產環境持續合規的直觀依據。無論是無菌灌裝區、潔凈走廊還是關鍵操作點,都需定期進行浮游菌測試,以評估環境潔凈度。
浮游菌采樣操作流程
1.采樣準備
操作人員需按潔凈區更衣流程穿戴相應潔凈服(如A.級/B級區需無菌更衣),避免化妝品、首飾等污染物帶入。
確認采樣區域已完成清潔消毒,且生產環境處于穩定狀態,HVAC系統運行至少30分鐘以上,確保氣流穩定。
檢查浮游菌采樣器外觀清潔度,確認設備按SOP定期校準,記錄在校準有效期內。準備經滅菌的采樣培養基可以使用大豆酪蛋白瓊脂SCDA,確認培養基滅菌有效性且在有效期內。
準備無菌采樣皿,根據采樣量選擇合適直徑,常用尺寸90mm,使用前需在生物安全柜內開蓋,避免污染。
根據監測目的、日常監測、動態監控、驗證等確定采樣點、采樣時間及采樣體積按潔凈級別設定,A、B級通常單次取樣1000L,C級500L,D級100L對采樣器的采樣頭、氣流通道等與樣品接觸的部件進行滅菌,如濕熱滅菌、環氧乙烷滅菌等方法。
在生物安全柜或潔凈工作臺內,將滅菌后的培養基平皿平穩放置于采樣器托盤上,確保皿蓋全打開,避免觸碰培養基表面。
2.采樣過程
具體參考《中國藥典》、GBT16293、ISO14644等法規標注。確認設備流量穩定通常為28.3L/min或100L/min,需與設備校準流量一致。按預設采樣點順序設置,便于數據追溯。
將采樣器放置于預設采樣點,高度通常與操作面或產品暴露高度一致離地0.8-1.5m,避免直接放置于回風口、設備出風口等氣流異常區域。
啟動采樣程序,確保采樣過程中設備穩定運行,無振動、噪音異常。采樣期間操作人員需保持距離,避免干擾氣流。
單一點位采樣結束后,關閉采樣器,在生物安全柜內蓋好平皿蓋子,標記采樣點編號、時間、操作人員等信息。
更換采樣點時,需對采樣頭表面進行消毒用75%無菌酒精擦拭,避免交叉污染。若采樣器需在不同潔凈級別區域移動,需先在低級別區域清潔消毒后,再進入高級別區域。

3.采樣分析
采樣完成后,將培養基平皿在規定時間內,通常≤4小時送至微生物實驗室,按標準條件培養,30-35℃培養5天,真菌需20-25℃培養7天。
記錄培養條件及時間,確保符合檢測規范。采樣結束后,對采樣器表面及采樣頭進行清潔消毒,按規定流程移出潔凈區。
非使用期間,設備需存放于清潔干燥的環境中,定期維護保養,完整記錄采樣信息:采樣點、時間、流量、體積、培養基批次、操作人員、設備編號等。
監測數據需及時錄入系統,與環境監測趨勢分析關聯,確保數據可追溯,異常數據需按偏差程序處理。
定期對采樣器的流量精度、計時準確性進行校準,校準記錄需存檔備查。操作流程需標準化、文件化,操作人員需經培訓合格后方可上崗,確保符合藥監審計要求。通過規范的操作流程,浮游菌采樣器3080可精準捕獲潔凈環境中的微生物,為制藥行業潔凈區管理提供可靠的數據支持。
免責聲明